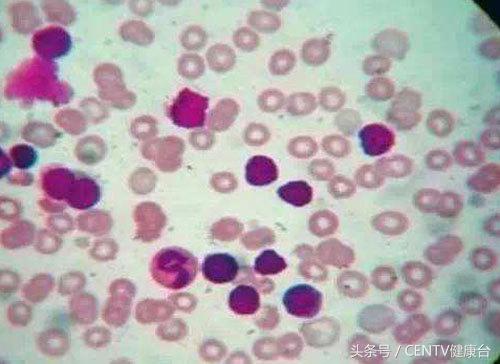
钻胯治病9元一次这样的奇耻大辱真的能治好白血病吗？

当人们面临绝境的时候,会想出一些办法,这些办法或许是效仿、或许是创新,但终归目的是让更多的人知晓自己的事情,从中能获取更多的帮助。

近日一则新闻,让人看后很心酸,重庆小龙坎轻轨站附近,23岁的女大学生李娟与51岁的母亲跪地,一边举着一块写有“钻胯治病 9元一次”字样的牌子,一边给路人派发A4纸求助信。究竟是因为什么,让李娟要这样做?

原来是,农村出身的李娟,在大二的时候,在一次兼职回家后突然晕倒,后被送到医院确诊为急性髓系白血病。之后,家里向亲戚朋友筹集60万元做了骨髓移植手术。上天有的时候是不公平的!不幸的是,李娟手术后期出现排异和感染,以及肾功能、肺功能衰竭。据悉,李娟虽已经做了移植手术,但还要经过排异、感染、复发三个阶段,才能度过危险期,需要3到5年左右,后期治疗费用保守估计需要三四十万元左右。

李娟说,家里能卖的已经卖光了,能借的已经借遍了,已经没有钱做后期治疗了。但如果不治疗就会前功尽弃!虽有很多人的质疑,但李娟坚信会有人理解她,并说钻胯的确是奇耻大辱,如此臭钱也是无奈之举。

因为长期吃激素药物,李娟的脸显得格外胖。
白血病离我们有多远?

白血病是一种常见的恶性肿瘤,是一类造血干细胞恶性克隆性疾病。表现为正常血细胞生成减少,周围血白细胞发生质和量的异常,白细胞及其幼稚细胞(即白血病细胞)在骨髓或其它造血组织中进行性、失控制的异常增生,浸润并损害各种组织,产生不同症状。
白血病的分类
1急性白血病

病情发展比较快,骨髓及周围血中主要是异常原始和幼稚细胞。其自然病程多在6个月以内。
急性白血病又分为:A、急性淋巴细胞白血病(急淋);B、急性非淋巴细胞白血病(急非淋)。包括急性粒细胞白血病(急粒)、急性单核细胞白血病(急单)。
2急性白血病

慢性白血病起病缓慢,早期多没有症状,常会在其他疾病验血的时候无意中发现。
自然病程多在一年以上。分为慢性髓细胞性白血病和慢性淋巴细胞白血病。
白血病为什么叫做白血病?

正常人和白血病患者抗凝全血静置沉积后的对比
白血病的早期症状

1、发热
发热急性白血病的首发症状多是发热

2、出血
出血是白血病的常见症状,出血部位可遍及全身,鼻腔、口腔、眼底为常见。

3、贫血
早期可发生贫血,面色发白、头晕等。
4、淋巴结肿大
淋巴结肿大,以颌下、颈部、锁骨上、腋下及腹股沟处多见,这是量白血病细胞浸润骨髓的表现。

5、骨、关节疼痛
可为肢体或背部弥漫性疼痛,亦可局限于关节痛,常导致行动困难。
白血病的诱发因素

滚蛋吧!白血病

白血病拥有爱情吗?
答案是肯定的,你终会遇到一个合适的人。无论生老病死,他(她)都会陪在你的左右。经历过疾病的爱情会更牢靠的!所以不要有心理压力,那个他(她)一定会在恰当的时候来到你的身边!
结语:在疾病面前,我们每个人都会显得很渺小,但不会被疾病所打败,会有各种各样的方法让我们活下去!李娟的方式或许有些极端,但为了生命,已经顾不了那么多了!我们每个人都要更加爱惜自己的身体,不要让它那么容易受到疾病的伤害!